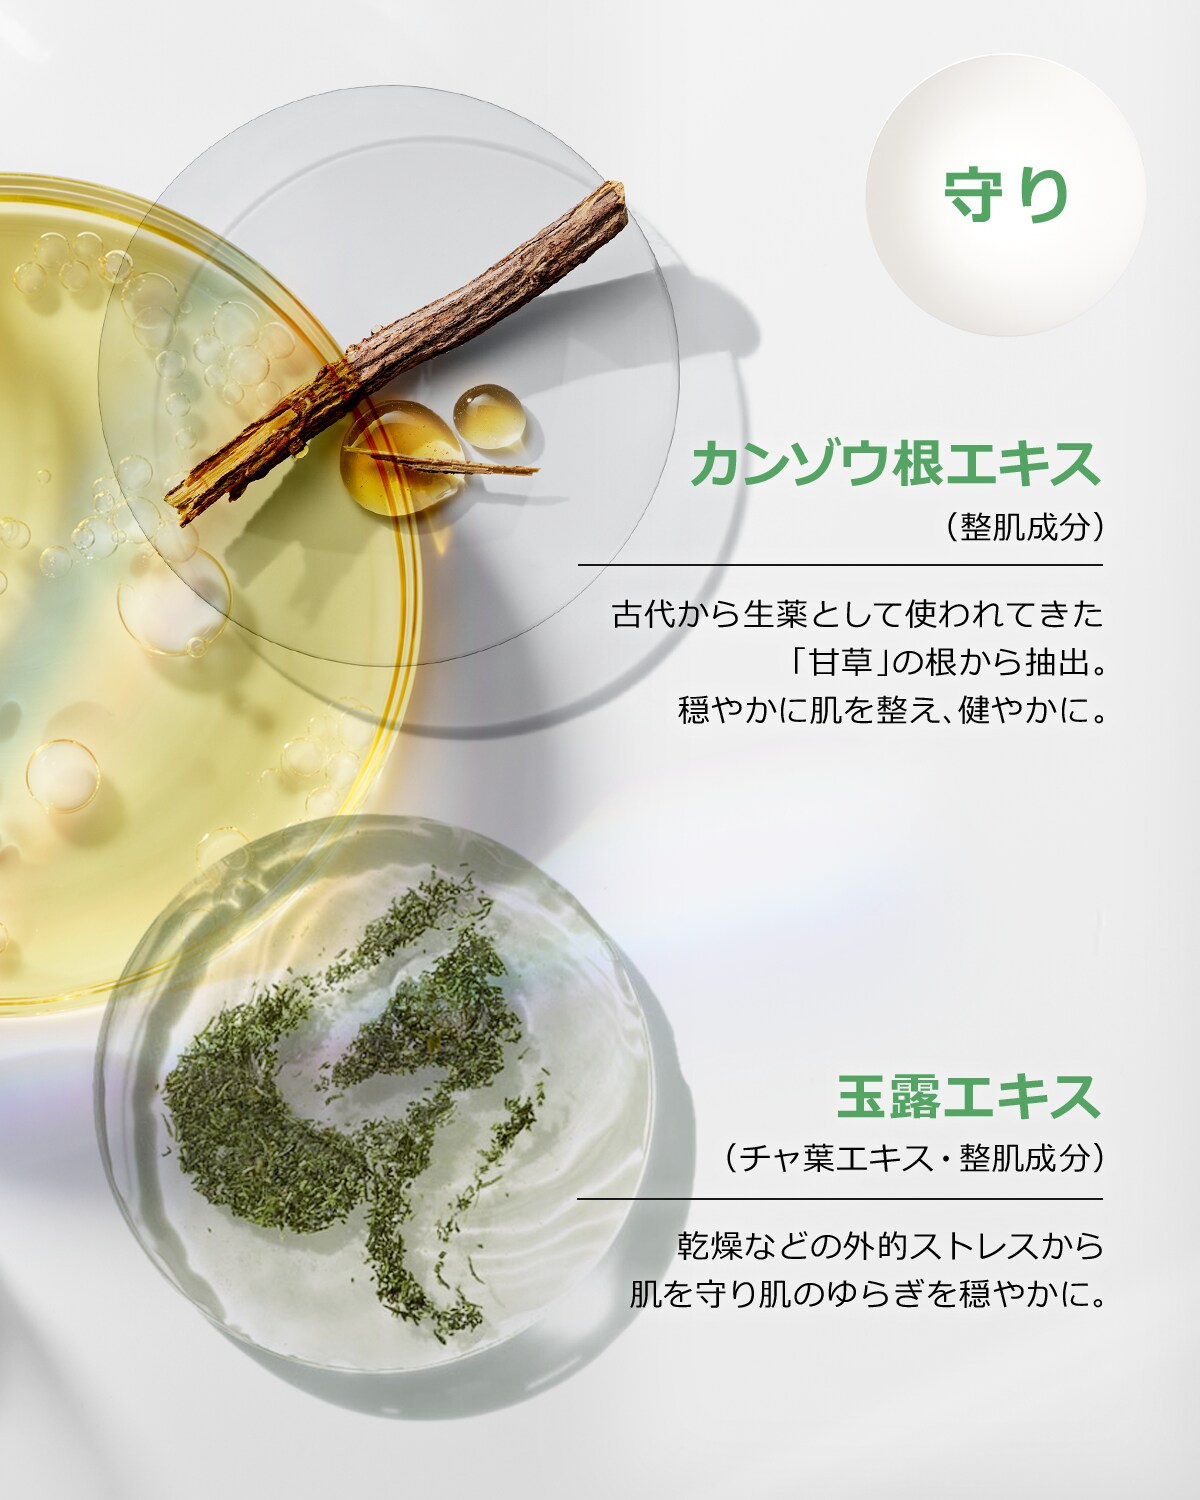

| You are currently signed in as: csr signout | Session open for : Reset customer | Customer Cart | QuikSearch |









EVEN BETTER SERUM 30 SET 26
ローディング...
税込
| You are currently signed in as: csr signout | Session open for : Reset customer | Customer Cart | QuikSearch |
| You are currently signed in as: csr signout | Session open for : Reset customer | Customer Cart | QuikSearch |